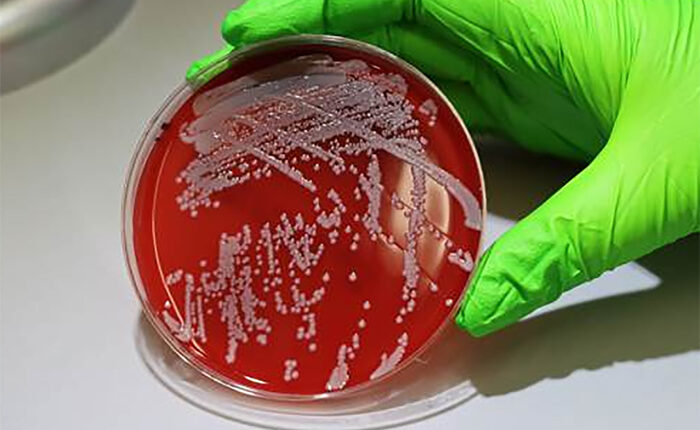

El superenemigo de la salud
Un estudio de Reino Unido indicó que si se abandonan las políticas para combatir la resistencia antimicrobiana, aumentarán las muertes por esta causa y tendrá un impacto negativo para las economías. Organismos no descartan una nueva pandemia a mediano plazo.

Las superbacterias –microorganismos que desarrollaron resistencia a muchos antibióticos– podrían causar la muerte de millones de personas alrededor del mundo y grandes daños en las economías nacionales, según un estudio financiado por el gobierno de Reino Unido. Estiman que para 2050 esta problemática podría costarle a la economía global una pérdida de casi 2 billones de dólares anuales.
El estudio tomó datos de 122 países y fue realizado por expertos del Center for Global Development. Sus resultados advierten que el aumento de las tasas de resistencia a los antimicrobianos (RAM) podría provocar estas grandes pérdidas anuales del PBI mundial, además del impacto en la salud humana y ambiental. Entre las economías más afectadas se encuentran China –con alrededor de 720 billones de dólares–, Estados Unidos –casi 300 billones–, Reino Unido –casi 60 billones–, Japón –cerca de 65 billones– y la Unión Europea –alrededor de 187 billones–.
La resistencia antimicrobiana se genera por el uso masivo de antibióticos, tanto en la salud humana como en las producciones agrícolas y ganaderas. Al exponerse frecuentemente a antimicrobianos, los microorganismos pueden adaptarse y volverse resistentes. La Organización Mundial de la Salud (OMS) ya había alertado el año pasado que para 2050 las muertes asociadas a la RAM doblarían la cifra y llegarían a las 10 millones, superando a las patologías oncológicas.
Motosierra al bienestar
Los resultados de la investigación se conocieron en un contexto internacional de políticas de ajuste en torno a la temática. El jueves el gobierno inglés anunció el recorte de la financiación del fondo Fleming, destinado al combate de la resistencia antimicrobiana en países de ingresos bajos y medios. Al mismo tiempo, el gobierno estadounidense confirmó otro recorte de cerca de 9 billones de dólares para el presupuesto de ayuda exterior. Esta tendencia se replica en diversos países europeos.
Anthony McDonnell, el autor principal de la investigación, indicó que al comenzar el estudio del impacto de esta resistencia se preveía que las tasas seguirían las tendencias históricas. “Sin embargo, los recortes repentinos a la Ayuda Oficial al Desarrollo por parte de EE. UU., que ha recortado su gasto en ayuda en aproximadamente un 80 %; el Reino Unido, que ha anunciado recortes de la ayuda del 0,5 % al 0,3 % del PBI; y las reducciones sustanciales de Francia, Alemania y otros países, podrían incrementar las tasas de resistencia, en línea con el escenario más pesimista de nuestra investigación“, alertó.
Por otra parte, el investigador subrayó que incluso los países que controlaron las tasas de la población resistente a los antimicrobianos “no pueden permitirse ser complacientes. Salvo que los programas de ayuda para la RAM estén protegidos de los recortes presupuestarios, es muy probable que las tasas de resistencia aumenten a lo largo del mundo”. Por esto, calculan que morirán millones de personas, incluso en los países más ricos.
El costo humano
De acuerdo con el Instituto de Métricas y Evaluación de Salud –dependiente de la Universidad de Washington–, se espera que las muertes relacionadas a la resistencia antimicrobiana aumenten un 60% en 25 años, afectando a 1,34 millones de personas en Estados Unidos y alrededor de 184 mil en Reino Unido anualmente. Además, las superbacterias incrementan el número de ingresos en los hospitales y a tratamientos más largos y costos. Se estima que los tratamientos para quienes tengan resistencia a los antimicrobianos son el doble de caros que los antibióticos tradicionales.
El doctor Mohsen Naghavi, profesor del Instituto, calcula que si los países invierten en combatir las superbacterias –en el acceso a nuevos antibióticos y tratamientos de alta calidad para estas infecciones– las economías podrían crecer. Por ejemplo, la economía estadounidense se ampliaría 156 billones de dólares anualmente. “Hoy en día, la amenaza de la RAM está aumentando y, sin una acción inmediata de todas las partes interesadas, los medicamentos a los que tenemos acceso podrían dejar de funcionar, lo que podría provocar que una simple infección se vuelva mortal”, explicó.
Políticas públicas de protección
Un vocero del gobierno de Reino Unido señaló: “Nuestro plan de salud a diez años reconoce la resistencia a los antimicrobianos (RAM) como una amenaza importante y se compromete a abordar urgentemente su propagación, incluso mediante nuevas vacunas”. En esta línea, consideró: “Hemos logrado avances importantes: hemos reducido el uso de antibióticos en la carne y hemos sido pioneros en un modelo de suscripción que incentiva el desarrollo de nuevos tratamientos. También seguimos colaborando estrechamente con socios internacionales para influir en los esfuerzos globales para limitar la propagación de la RAM”.
De todas formas, Argentina fue pionera en la región con la Ley Nacional de Prevención y Control de la resistencia a los antimicrobianos (N° 27.680), que aborda la prevención y el control de la resistencia antimicrobiana y plantea un “trabajo conjunto de los sectores de la salud humana, animal y ambiental”. La autoridad regulatoria nacional que plantea la ley es la ANMAT que actualmente también sufre la desfinanciación y el recorte de tareas.
A partir de su sanción en 2022, nuestro país consideró que la RAM es uno de los “principales problemas de salud pública a nivel mundial” y que el uso de antimicrobianos –en especial los antibióticos– es “masivo” y “muchas veces inadecuado”, ya que son usados sin justificación, sin seguir las indicaciones prescriptas, duración e intervalo de tomas, entre otros.
La Organización Panamericana de la Salud (OPS) resaltó la importancia de esta ley y la calificó de “sobresaliente”, destacando el enfoque más amplio que lo humano. Sin embargo, el organismo alertaba que sin una respuesta mundial, conjunta y sistematizada para el 2050 la RAM podría ser la primera causa de muerte a nivel mundial y a mediano plazo la fuente de futuras pandemias. A su vez, reiteraba que las poblaciones más vulnerables serán las que sufrirán el mayor impacto humano.

Los comentarios están cerrados.